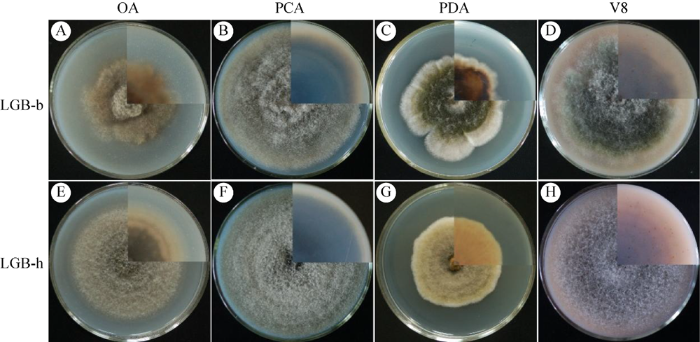

昆诺阿藜Chenopodium quinoa Willd.是苋科藜属一年生双子叶植物,原产于南美洲(Zurita-Silva et al. 2014),有“粮食之母”的美称。近年来,由于其营养价值突出而备受人们关注(Bhargava et al. 2006;Vega-Gálvez et al. 2010),被认为是功能性食品的典范(Singh et al. 2016)。此外,昆诺阿藜具有耐寒、耐旱、耐盐碱等特性,对农业生态系统的发展具有重要意义(Graf et al. 2015)。昆诺阿藜在我国主要分布在内蒙古、西藏、青海、甘肃、山西、河北等地区(任贵兴等 2015);国内已报道的昆诺阿藜病害主要有霜霉病(殷辉等 2018)、叶斑病(殷辉等 2019;Brahmanage et al. 2020;王建鹏等 2020)、黑茎病(Yin et al. 2020)、病毒病(Sun et al. 2021)和穗腐病(Yin et al. 2022)等,病害种类越来越多,严重制约着昆诺阿藜产业的发展。
已报道的昆诺阿藜叶部病害有5种,分别为拟壳格孢叶斑病病原Ascochyta hyalospora (Boerema et al. 1977)、霜霉病病原Peronospora variabilis (殷辉等 2018)、尾孢叶斑病病原Cercospora cf. chenopodii (殷辉等 2019)、穿孔叶斑病病原Heterosporicola beijingense (Brahmanage et al. 2020)和链格孢叶斑病病原Alternaria alternata (王建鹏等 2020)。山西省已报道的昆诺阿藜叶斑病主要是霜霉病和尾孢叶斑病(殷辉等 2018,2019)。2019-2020年,在山西省昆诺阿藜种植区发现了链格孢叶斑病,发病初期在叶片上形成圆形、近圆形或椭圆形病斑;后期多个病斑易连接成一个大的不规则状病斑,叶片卷曲、开裂、易脱落;发病率约为30%,严重地块约65%。
链格孢属Alternaria Nees真菌在世界上广泛分布,可寄生4 000多种植物(Lawrence et al. 2016)。近百年来,链格孢属的分类标准及属的界限发生了较大变化,传统上鉴定链格孢菌主要依靠形态特征,然而许多研究学者发现其形态特征易受到营养条件、pH、温度、光照等环境条件影响,特别是一些小孢子链格孢种(Simmons 1992;张荣等 2009;冯中红和孙广宇 2020)。目前,联合形态特征与多基因序列(如Alt a 1、endoPG、gapdh、OPA10-2、rpb2和tef1等)对链格孢属真菌进行鉴定的方法非常普遍(岳海梅等2007;Woudenberg et al. 2015;冯中红和孙广宇 2020;王文青等 2020)。王建鹏等(2020)在西藏林芝发现了昆诺阿藜链格孢叶斑病,病原鉴定为A. alternata,遗憾的是没有对其进行系统性研究。本研究系统描述了昆诺阿藜链格孢叶斑病的症状特征,采用形态特征与系统发育分析(Alt a 1、endoPG 和OPA10-2)相结合的方法对病原菌进行鉴定,并对其致病性及生物学特性进行了研究,以期为该病害的诊断和防治提供依据。
1 材料与方法
1.1 供试材料
1.1.1 病害调查和病样标本采集
2019-2020年在山西省昆诺阿藜种植区(静乐、神池、五台、原平和榆次)调查记录不同发病时期的症状特征,采集典型症状的叶片带回实验室。
1.1.2 培养基、仪器和设备
1.2 病原菌分离和纯化
采用组织分离法(方中达 1998),选取典型症状的叶片,取病健交界处组织,大小约3 mm× 3 mm,经75%乙醇表面消毒25 s,无菌水冲洗4次,置于PDA平板上25 ℃黑暗培养,单孢纯化后的菌株接种于PDA斜面,4 ℃冰箱保存。
1.3 病原菌形态学鉴定
采用链格孢菌形态学鉴定的常用培养基(OA、PCA、PDA和V8)进行形态学研究(罗欢 2019;石延霞等 2019;孟祥龙等 2021),将代表性菌株接种在上述4种鉴别培养基上25 ℃培养6 d,观察菌落形态(包括颜色、形状和表面性状等),计算生长速率等情况。PCA上培养6 d 后,在Olympus BX 53型显微镜下观察、测量代表性菌株上的分生孢子、分生孢子梗等显微特征(张天宇 2003),每个菌株统计50个分生孢子的大小、横隔和纵隔数(Simmons & Roberts 1993);用无菌手术刀切除1 cm×1 cm的菌块,继续培养3 d 后在Nikon SMZ18体式显微镜下观察切口处代表性菌株的分生孢子链及其分枝特征。
1.4 病原菌分子生物学鉴定
收集代表性菌株培养6 d的菌丝,液氮研磨,采用DNA抽提试剂盒提取DNA。应用引物对各菌株的Alt a 1、endoPG和OPA10-2进行扩增(表1),扩增程序为:95 ℃预变性5 min;95 ℃变性90 s,57 ℃退火90 s,72 ℃延伸60 s,35个循环;最后72 ℃再延伸10 min。PCR产物送至生工生物工程(上海)股份有限公司测序,将测序结果提交至GenBank,获得序列号(表2)。以A. tomato(CBS 103.30)为外群,基于代表性菌株和相关菌株的Alt a 1、endoPG 和OPA10-2基因序列,采用邻接法(neighbor-joining,软件PAUP* v. 4.0b10)进行系统发育分析,重复1 000次、计算进化树内每个分支的bootstrap值(Swofford 2003)。
表1 本研究中涉及的引物
Table 1
| 基因 Gene | 引物 Primer | 序列 Sequence (5′→3′) | 参考文献 Reference |
|---|---|---|---|
| Alt a 1 | Alt a 1-F | GCTGCACCTCTCGAGTCTC | Woudenberg et al. (2014) |
| Alt a 1-R | AAGTCCTTAGGGCCGTTACC | ||
| endoPG | endoPG-F | GGCACAACTTTGGACCTCTC | Andrew et al. (2009) |
| endoPG-R | TGATGACGTTGTTGCTGGAG | ||
| OPA10-2 | OPA10-2-F | TTAGTGCAGCTCTCTCAAACG | Andrew et al. (2009) |
| OPA10-2-R | TTGAACTTCGTAACCAGGGC |
表2 用于多基因序列分析的菌株及序列登录号
Table 2
| 现用名 Current name | 异名 Synonym | 菌株号 Strain No. | GenBank 登录号 GenBank accession number | ||
|---|---|---|---|---|---|
| Alt a 1 | endoPG | OPA10-2 | |||
| Alternaria alstroemeriae | CBS 118808 | KP123845 | KP123993 | KP124601 | |
| A. alternata | LGB-b | OL505082 | OL505080 | OL455873 | |
| A. alternata | LGB-h | OL505083 | OL505081 | OL455874 | |
| A. alternata | A. pulvinifungicola | CBS 194.86 | KP123869 | KP124016 | KP124623 |
| A. alternata | A. rhadina | CBS 595.93 | JQ646399 | KP124020 | KP124627 |
| A. alternata | A. tenuissima | CBS 918.96 | AY563302 | KP124026 | KP124633 |
| A. alternata | A. limoniasperae | CBS 102595 | AY563306 | KP124029 | KP124636 |
| A. alternata | A. citrimacularis | CBS 102596 | KP123877 | KP124030 | KP124637 |
| A. alternata | A. citriarbusti | CBS 102598 | KP123878 | KP124031 | KP124638 |
| A. alternata | A. turkisafria | CBS 102599 | KP123879 | KP124032 | KP124639 |
| A. alternata | A. perangusta | CBS 102602 | KP123881 | AY295023 | KP124641 |
| A. alternata | A. interrupta | CBS 102603 | KP123882 | KP124034 | KP124642 |
| A. alternata | A. dumosa | CBS 102604 | AY563305 | KP124035 | KP124643 |
| A. alternata | A. tomaticola | CBS 118814 | KP123906 | KP124059 | KP124669 |
| A. alternata | A. vaccinii | CBS 118818 | KP123908 | KP124061 | KP124671 |
| A. alternata | A. citricancri | CBS 119543 | KP123911 | KP124065 | KP124674 |
| A. alternata | A. platycodonis | CBS 121348 | KP123915 | KP124070 | KP124679 |
| A. gaisen | CBS 118488 | KP123975 | KP124132 | KP124743 | |
| A. gossypina | CBS 104.32 | JQ646395 | KP124135 | KP124746 | |
| A. gossypina | A. tangelonis | CBS 102597 | KP123978 | KP124137 | KP124748 |
| A. gossypina | A. colombiana | CBS 102601 | KP123979 | KP124138 | KP124749 |
| A. longipes | CBS 539.94 | KP123987 | KP124146 | KP124757 | |
| A. longipes | CBS 540.94 | AY563304 | KP124147 | KP124758 | |
| A. tomato | CBS 103.30 | KP123991 | KP124151 | KP124762 | |
注:加粗部分为本研究菌株
Note: The bold parts are strains of this study.
1.5 致病性测定
选取盆栽60 d的昆诺阿藜苗,将叶片经无菌水冲洗后自然风干,分别进行创伤和无创伤接种。用3号昆虫针在叶片表面轻轻刺伤(3-4个微伤口),从培养6 d的代表性菌株的菌落上取菌饼(直径5 mm),接种于叶片的伤口处,每个处理5株苗、每株7片叶,接种PDA为对照。
收集在PDA上培养6 d的代表性菌株的分生孢子,配成孢悬液(1×105个/mL)。将孢悬液喷雾于叶片进行无创伤接种,每个处理5株苗、每株约10片叶,接种无菌水为对照。接种后保湿置于人工气候箱中(温度22-26 ℃、RH 75%±5%),观察记录发病情况和病斑直径。发病后采集典型症状叶片,从病斑处重新分离病原菌,观察对比再分离菌株与接种菌株的形态特征。
1.6 不同温度下病原菌对昆诺阿藜、藜和台湾藜离体叶片的致病力测定
供试植株为红昆诺阿藜Chenopodium quinoa (品种未知)、白昆诺阿藜C. quinoa (品种:稼祺505)、白昆诺阿藜C. quinoa (品种:静藜1号,静乐县农技推广中心)、藜C. album、台湾藜C. formosanum,取各植株盆栽60 d的叶片,将叶片用75%乙醇进行表面消毒,再用无菌水浸湿的棉花覆盖叶柄保湿,置于直径为90 mm的无菌培养皿中(每皿1片叶子)准备接种。将代表性菌株接种于PDA上25 ℃培养6 d,从菌落边缘取直径5 mm的菌饼接种于离体叶片上(每叶片接1枚菌饼),以接种PDA培养基为对照,置于温度梯度为10、15、20、25和30 ℃,RH 75%± 5.0%的环境中进行培养,重复5次;培养6 d后观察记录发病情况和病斑直径。
1.7 病原菌的生物学特性研究
1.7.1 温度对菌丝生长的影响
设置10、15、20、25和30 ℃ 5个温度梯度,将代表性菌株在PDA上25 ℃黑暗培养6 d后,从菌落边缘取直径5 mm菌饼接种于PDA平板中央,置于不同温度下恒温黑暗培养,重复3次;培养6 d后用十字交叉法测量菌落直径,计算菌丝生长速率。
1.7.2 水活度对菌丝生长和分生孢子萌发的影响
水活度对菌丝生长的影响:分别将体积为0、143、193、218、293、343和393 mL的甘油添加至灭菌后冷却至80 ℃的1 L PDA中;调节其水活度值依次为1.00、0.98、0.96、0.94、0.92、0.90和0.88,最后用Pawkit水活度仪(Decagon,USA)测量上述PDA的水活度值。将代表性菌株接种于上述不同水活度的PDA,重复3次;置于25 ℃培养6 d,计算菌丝生长速率。
水活度对分生孢子萌发的影响:采用涂片法(臧睿和黄丽丽 2007),取1 mL不同水活度值的PDA均匀涂布于无菌载玻片(大小约2.5 cm×4.0 cm;厚度约1 mm),为防止PDA涂片变干,凝固后将其置于RH 75%的干燥器中(NaCl饱和盐溶液)。静置约2 h,将20 μL孢悬液(1×105个/mL)接种至上述涂片。最后将干燥器置于25 ℃培养箱,重复3次;6 h后镜检500个分生孢子的萌发情况,计算孢子萌发率。
1.7.3 pH对菌丝生长和分生孢子萌发的影响
pH对菌丝生长的影响:将PDA冷却至约80 ℃ (pH 5.8-6.1),在无菌环境中取适量的HCl溶液(1 mol/L)加入PDA并充分摇匀,进而调节PDA的酸度。调节时,使用PHS-4C+酸度计监测PDA的pH值,直至pH值依次为2、3、4、5和6 (波动范围±0.1)。调节PDA的碱度时使用NaOH溶液(1 mol/L),将其pH值调节至7、8、9、10、11和12 (方法同上)。将代表性菌株接种于不同pH的PDA,重复3次;25 ℃培养6 d,计算菌丝生长速率。
pH对分生孢子萌发的影响:采用涂片法(臧睿和黄丽丽 2007),取1 mL不同pH值的PDA均匀涂布于无菌载玻片(大小约2.5 cm×4.0 cm;厚度约1 mm),为防止PDA涂片变干,凝固后将其置于RH 75%的干燥器中(NaCl饱和盐溶液)。静置约2 h,将20 μL孢悬液(1×105个/mL)接种至上述涂片。最后将干燥器置于25 ℃培养箱,重复3次;6 h后镜检500个分生孢子的萌发情况,计算萌发率。
2 结果与分析
2.1 病害症状
图1
图1
昆诺阿藜链格孢叶斑病田间症状
A:发病初期;B-D:发病中期;E,F:发病后期
Fig. 1
Symptoms of quinoa Alternaria leaf spot disease under natural infection.
A: Symptoms at early stage; B-D: Symptoms at middle stage; E, F: Symptoms at late stage.
2.2 病原菌的形态学特征
本研究共分离得到21株病原菌,依据在各培养基上的菌落形态特征(颜色、质地等)分为2类,选取LGB-b和LGB-h作为代表性菌株进行系统性研究。代表性菌株在4种鉴别培养基上气生菌丝发达呈绒毛状或棉絮状,菌落正面黄棕、灰棕或深绿色,背面棕、灰褐或黑褐色。
图2
图2
代表性菌株在OA、PCA、PDA和V8培养基上的菌落正面和背面
右上角为背面菌落特征
Fig. 2
Colonies on observe and reverse of OA, PCA, PDA, and V8 plates of the representative isolates of Alternaria alternata at 25 °C in 6 d.
Top right quadrants of images are the view of reverse colony.
图3
图3
PCA上代表性菌株的显微形态特征
A,D:分生孢子梗;B,E:分生孢子;C,F:分生孢子链及其分枝特征. 标尺:A,D=20 μm;B,E=5 μm;C,F=100 μm
Fig. 3
Microscopic characteristics of representative isolates of Alternaria alternata on PCA plate.
A, D: Conidiophores; B, E: Conidia; C, F: Conidial chains and branches. Bars: A, D=20 μm; B, E=5 μm; C, F=100 μm.
代表性菌株LGB-b和LGB-h在显微形态上略有差异,菌株LGB-b的分生孢子梗(大小16.8-109.4×2.9-5.5 μm,平均54.1×4.1 μm)相比LGB-h略大(大小9.8-100.5×2.6-4.7 μm,平均40.1×3.9 μm)。菌株LGB-b (1-3个横隔膜、0-2个纵隔膜)相比LGB-h (3-5个横隔膜、0-1个纵隔膜)横隔膜较少、纵隔膜较多。菌株LGB-b的分生孢子(大小10.6-33.8×5.3-12.5 μm,平均21.4× 8.9 μm)相比LGB-h (大小10.4-40.4×5.7-12.8 μm、平均21.6×9.3 μm)略小。
2.3 基于Alt a 1、endoPG和OPA10-2序列的系统发育分析
扩增菌株LGB-b和LGB-h的Alt a 1、endoPG和OPA10-2的基因序列,并将获得的序列提交至GenBank (表2)。以A. tomato (CBS 103.30)为外类群构建系统发育树,结果表明,菌株LGB-b和LGB-h与14株A. alternata聚为一支,支持率77%。在A. alternata株系间,系统发育树显示了种内多样性。菌株LGB-b与CBS 102599、CBS 102603、CBS 102602、CBS 102595、CBS 102604、CBS 119543、CBS 918.96和CBS 102596 聚类在一起,形成一个亚分支,支持率87%;而菌株LGB-h与CBS 194.86、CBS 121348、CBS 595.93、CBS 102598、CBS 118814和CBS 118818聚为另一个亚分支,支持率97% (图4)。
图4
图4
基于Alt a 1、endoPG和OPA10-2构建的系统发育树
Fig. 4
Phylogenetic tree based on Alt a 1, endoPG, and OPA10-2 genes of isolates LGB-b and LGB-h, and their related strains.
2.4 病原菌的致病性
创伤接种菌株LGB-b,6 d后病斑表面灰绿色,具有灰棕色霉层,周围出现黄绿色晕圈,直径为0.7-0.8 cm (图5B);15 d后叶片皱缩、卷曲,表面具有大量灰绿色霉层,直径为3.0-3.5 cm (图5C),对照未发病(图5A)。创伤接种菌株LGB-h,6 d后叶斑呈黄绿色,具有灰褐色霉层,周围出现黄绿色晕圈,直径为0.7-1.0 cm (图5E);15 d后叶片皱缩,表面具有大量黑褐色霉层,直径为3.2-3.6 cm (图5F),对照未发病(图5D)。喷雾接种菌株LGB-b,6 d后叶片正面出现零星黄绿色小点,病斑表面黄棕色,直径为0.4-0.6 cm (图5H);8 d后病斑表面黄褐色,具有灰褐色霉层,周围具黄绿色晕圈,直径为0.6-0.9 cm (图5I);对照未发病(图5G)。喷雾接种菌株LGB-h,6 d后叶片正面病斑表面灰棕色,直径为0.5-0.7 cm (图5K);8 d后病斑表面浅黄棕色,具有灰棕色霉层,周围具轻微黄绿色晕圈,直径为0.7-1.1 cm (图5L),对照未发病(图5J)。致病性接种叶片发病症状与田间症状基本一致(图1B,1C),从叶片发病部位再分离的菌株与接种菌株的形态一致,符合柯赫氏法则,表明LGB-b和LGB-h为致病菌。
图5
图5
创伤和无伤接种代表性菌株的症状
Fig. 5
Symptoms induced by isolates LGB-b and LGB-h of Alternaria alternata on wounded and unwounded leaves in different days of postinoculation (dpi).
2.5 不同温度下病原菌对昆诺阿藜、藜和台湾藜离体叶片的致病力
接种菌株LGB-b后,温度为15-30 ℃时在红昆诺阿藜品种的叶片正面病斑呈灰绿至黄棕色,具黄绿色晕圈,直径为0.8-1.6 cm (图6)。温度为10-30 ℃时,在白昆诺阿藜品种的叶片正面病斑中间黄绿至灰绿色,边缘黄绿至黄棕色,表面具有深棕或灰绿色霉层,直径为1.5-2.1 cm (图6)。侵染静藜1号和稼祺505叶片的最适温度分别为15-30 ℃和20-30 ℃,且静藜1号的病斑比稼祺505大,直径分别为1.8-2.1 cm和1.5-1.9 cm (图6)。温度为10-30 ℃时,接种菌株LGB-b在藜和台湾藜叶片正面病斑分别呈黄棕色和灰绿色,具黄绿色晕圈,直径分别为0.4-0.8 cm和0.8-1.3 cm (图6)。
图6
图6
菌株LGB-b接种昆诺阿藜、藜和台湾藜后不同温度下的症状
Fig. 6
Symptoms induced by inoculations of Alternaria alternata LGB-b on detached leaves of Chenopodium quinoa, C. album, and C. formosanum at 10 °C, 15 °C, 20 °C, 25 °C, and 30 °C.
图7
图7
菌株LGB-h接种昆诺阿藜、藜和台湾藜后不同温度下的症状
Fig. 7
Symptoms induced by inoculations of Alternaria alternata LGB-h on detached leaves of Chenopodium quinoa, C. album, and C. formosanum at 10 °C, 15 °C, 20 °C, 25 °C, and 30 °C.
2.6 培养基、温度、水活度、pH对病原菌生物学特性的影响
2.6.1 培养基对菌丝生长的影响
图8
图8
培养基(A)、温度(B)、水活度(C,D)和pH (E,F)对代表性菌株的菌丝生长和分生孢子萌发的影响
不同小写字母表示差异显著(P<0.05)
Fig. 8
Effects of media (A), temperature (B), water activity (aw) (C, D), and pH (E, F) on mycelial growth and conidial germination of representative isolates of Alternaria alternata.
Significant differences are shown by different lowercase letters (P<0.05).
2.6.2 温度对菌丝生长的影响
2.6.3 水活度对菌丝生长和分生孢子萌发的影响
2.6.4 pH对菌丝生长和分生孢子萌发的影响
3 讨论
链格孢可引起多种植物的叶斑病;国内外研究学者发现油菜链格孢叶斑病、樱桃链格孢叶斑病、芹菜链格孢叶斑病等在温度偏高、湿度偏大的条件下发生较重(Blagojević et al. 2020;刘俏等 2021;张建强等 2021)。昆诺阿藜链格孢叶斑病通常在显序期到灌浆期发生,为害叶片造成圆形或近圆形病斑,严重时多个病斑易连接成一个大的不规则状病斑,叶片枯黄易脱落。田间调研时发现河滩地块在气温较高时发病较重,高山、丘陵通风较好且冷凉地块发病较轻;田间温度为(25±3) ℃,RH 60%±10%范围内发病较快。此外,调查发现昆诺阿藜叶斑通常出现在叶片基部凹陷处,可能与叶基部凹陷、易积水、湿度偏大有关。
本研究综合形态特征和多基因系统发育分析,确定引起昆诺阿藜链格孢叶斑病病原为Alternaria alternata。A. alternata 是链格孢属常见的植物病原菌,可以侵染甜菜、藜、菠菜、昆诺阿藜等苋科植物引起叶斑病和穗腐病等病害(Franc 2009;Patel et al. 2014;Gilardi et al. 2019;王建鹏等 2020;Yin et al. 2022)。与王建鹏等(2020)报道的由A. alternata引起的叶斑病相比,本研究所发现的链格孢叶斑病后期更容易使叶片开裂、卷曲,且在山西省昆诺阿藜叶片上寄生的A. alternata 的分生孢子与西藏地区相比在形态(孢子横、纵隔更少)和大小(孢子略小)上略有不同。Yin et al. (2022)在山西省发现了由A. alternata引起的昆诺阿藜穗腐病,本研究发现在昆诺阿藜叶片上寄生的A. alternata在形态、大小等方面与昆诺阿藜穗上的相似。通过对比山西和西藏地区昆诺阿藜上的A. alternata,发现其形态特征在不同环境条件下呈现多样性。
国内外学者研究表明A. alternata 的种群复杂多样(Woudenberg et al. 2015;Lakshmi Prasad et al. 2020;王文青 2021)。Woudenberg et al. (2015)对链格孢属的15个种进行了全基因组比对分析,发现A. alternata 遗传多样性比较丰富,大致分为6个群体。Lakshmi Prasad et al. (2020)将30株向日葵叶枯病菌A. alternata 分为3个群体,3个群体在形态特征、显微特征、致病性等方面呈现多样性;致病性分析发现群体2的致病力较强、群体2的平均分生孢子比群体3略大。张斌等(2020)研究发现49株柑橘黑腐病和黑斑病菌A. alternata 在致病力上存在差异。王文青(2021)将74株梨黑斑病菌A. alternata分为3个群体,在分生孢子形态、致病力等方面存在多样性,其中优势群体为中等致病力群体,占比75%。本研究中21株A. alternata 依据形态特征分为2个群体,分别以菌株LGB-b和LGB-h为代表,利用Alt a 1、endoPG和OPA10-2分析发现菌株LGB-b和LGB-h都归属于A. alternata;研究发现菌株LGB-b的分生孢子梗相比LGB-h更长更宽,分生孢子略小、横隔膜更少,菌株LGB-h 致病力强于LGB-b,这说明A. alternata不同分离株之间在形态特征、致病力、分子生物学等方面存在多样性。由于目前尚未明确界定A. alternata种的界限,多数菌株被归为或从A. alternata中分离出来,且包含A. alternata在内的组群(section Alternaria)内种的关系仍存在许多争议(冯中红和孙广宇 2020)。本研究样本来自山西省,关于我国昆诺阿藜链格孢叶斑病原种群的多样性有待深入研究。
本研究发现菌株LGB-b和LGB-h可以侵染昆诺阿藜、藜、台湾藜。因此,要密切关注昆诺阿藜、台湾藜及田间藜属杂草链格孢叶斑病的发生动态。本研究发现菌株LGB-h相比LGB-b具有较强致病力,通常菌株LGB-h在昆诺阿藜、藜、台湾藜的叶片上造成的病斑大。此外,研究发现红昆诺阿藜品种对菌株LGB-h的抗病性较强。因此,科学利用抗病品种有利于控制链格孢叶斑病的发生。在温度为20-30 ℃接种菌株LGB-b和LGB-h,侵染昆诺阿藜叶片后产生的病斑较大。因此,在湿度大的种植区要密切关注20-30 ℃时昆诺阿藜叶斑的发病情况。
国内外研究学者发现A. alternata尽管在种上一致,但在种内存在明显的生物学上的差异,如分离自高粱的A. alternata在中性条件下生长最好(赵艳琴等 2021),分离自玉米的A. alternata喜欢中性偏碱的环境(王媛媛等 2015)。本研究发现菌株LGB-b和LGB-h在弱酸条件下(pH为6-7)生长最好;菌株LGB-b的分生孢子更偏好弱酸环境(pH为6-7),而LGB-h的分生孢子在弱碱环境萌发率更高(pH为7-8)。温度对菌株LGB-b和LGB-h有显著影响,LGB-b在温度偏高时(25-30 ℃)生长较快,而菌株LGB-h适宜生长的温度相对冷凉(20-25 ℃)。水活度对病原菌的生长、繁殖及孢子的存活有重要意义。本研究发现水活度对菌株LGB-b和LGB-h的分生孢子萌发有显著影响,菌株LGB-b的分生孢子在较低的自由水环境中萌发率较高(水活度≤0.94),表明其适应性更广。不同的A. alternata菌株间在温度、pH、致病力等方面存在差异的原因可能与病原菌的寄主和采集地不同有关。
参考文献
An expanded multilocus phylogeny does not resolve morphological species within the small-spored Alternaria species complex
Small-spored Alternaria species are a taxonomically challenging group of fungi with few morphological or molecular characters that allow unambiguous discrimination among taxa. The protein-coding genes most commonly employed in fungal systematics are invariant among these taxa, so noncoding, anonymous regions of the genome were developed to assess evolutionary relationships among these organisms. Nineteen sequence-characterized amplified regions (SCAR) were screened for phylogenetic utility by comparing sequences among reference isolates of small-spored Alternaria species. Five of nineteen loci were consistently amplifiable and had sufficient phylogenetic signal. Phylogenetic analyses were performed with 150 small-spored Alternaria isolates using sequence data from an endopolygalacturonase gene and two anonymous loci. Associations among phylogenetic lineage, morphological classification, geography and host were evaluated for use as practical taxonomic characters. Samples included isolates from citrus in Florida, pistachio in California, desert plants in Arizona, walnuts in France/Italy and apples in South Africa. No associations were found between host or geographic associations and phylogenetic lineage, indicating that these characters were not useful for cladistic classification of small-spored Alternaria. Similarly strict congruence between morphology and phylogenetic lineage was not found among isolates grouped morphologically with A. alternata or A. tenuissima. In contrast 34 isolates grouped morphologically with A. arborescens fell into discrete clades for all datasets. Although 5-9 well supported clades were evident among isolates, it is currently unclear if these clades should be considered phylogenetic species or emerging evolutionary lineages within the phylogenetically defined alternata species-group.
Chenopodium quinoa-an Indian perspective
DOI:10.1016/j.indcrop.2005.04.002 URL [本文引用: 1]
Occurrence and characterization of Alternaria species associated with leaf spot disease in rapeseed in Serbia
DOI:10.1111/ppa.13168 URL [本文引用: 1]
Ascochyta hyalospora (Cooke & Ell.) comb. nov. in seeds of Chenopodium quinoa
Heterosporicola beijingense sp. nov. (Leptosphaeriaceae, Pleosporales) associated with Chenopodium quinoa leaf spots
Biology and physiology of Colletotrichum acutatum strains causing strawberry’s anthracnose
DOI:10.4236/as.2018.98068 URL [本文引用: 1]
Advances in the classification of Alternaria and related genera
Alternaria leaf spot
In:
Influence of the water activity of a solid substrate on the growth rate and sporogenesis of filamentous fungi
DOI:10.1002/bit.260310510 URL [本文引用: 1]
First report of Alternaria alternata causing leaf spot on spinach (Spinacia oleracea) in Italy
Innovations in health value and functional food development of quinoa (Chenopodium quinoa Willd.)
DOI:10.1111/1541-4337.12135 URL [本文引用: 1]
Report and biological characteristics to new strain of Colletotrichum acutatum species complex causing anthracnose in rubber trees
Population structure of Alternaria species causing leaf blight of sunflower (Helianthus annuus L.) in India
DOI:10.1007/s12600-020-00796-6 URL [本文引用: 2]
Biodiversity and taxonomy of the pleomorphic genus Alternaria
DOI:10.1007/s11557-015-1147-7 URL [本文引用: 1]
Biological characteristics of pathogen causing leaf spot disease of cherry in Qinghai province and toxicity test of different fungicides in laboratory
Diversity of pathogenic large-spored Alternaria from Compositae in China
Primary study on the symptoms and pathogen of apple fruit black spot diseases in Hebei Province
First report of Alternaria alternata on Chenopodium album L. from India
Effect of water activity and temperature on growth of Alternaria alternata on a synthetic tomato medium
DOI:10.1016/j.ijfoodmicro.2009.07.018
PMID:19683824
[本文引用: 1]

Alternaria alternata is a toxigenic fungus, predominantly responsible for Blackmould of ripe tomato fruits, a disease frequently causing substantial losses of tomatoes, especially those used for canning. The objective of this study was to determine the effect of water activity (a(w), 0.904, 0.922, 0.954, 0.982) and temperature (6, 15, 21 and 35 degrees C) on germination and radial growth rate on a synthetic tomato medium of a cocktail inoculum of five strains of A. alternata isolated from tomato fruits affected by Blackmould. The shortest germination time (1.5 days) was observed at 0.982 a(w), both at 21 degrees C and 35 degrees C. The germination time increased with a reduction on a(w). The fastest growth rate was registered at 0.982 a(w) and 21 degrees C (8.31 mm/day). Growth rates were higher when a(w) increased. No growth or germination was observed at the lowest a(w) level evaluated (0.904) after 100 days of incubation at 6 degrees C and 15 degrees C. A temperature of 6 degrees C caused a significant reduction in growth rates, even at the optimum a(w) level. The knowledge on the ecophysiology of the fungus in this substrate is necessary to elaborate future strategies to prevent its development and evaluate the consumer health risk.
Water activity and temperature effects on mycotoxin production by Alternaria alternata on a synthetic tomato medium
DOI:10.1016/j.ijfoodmicro.2010.07.017
PMID:20688408
[本文引用: 1]

Alternaria spp. have been reported to be the most frequent fungal species invading tomatoes. Certain species, in particular the most common one, A. alternata, are capable of producing several mycotoxins in infected plants and in agricultural commodities. Alternariol (AOH), alternariol monomethyl ether (AME), and tenuazonic acid (TA) are some of the main Alternaria mycotoxins that can be found as contaminants of food. The objective of this study was to determine the effect of water activity (a(w), 0.904, 0.922, 0.954, and 0.982) and temperature (6, 15, 21 and 35 degrees C) on mycotoxin production on a synthetic tomato medium of a cocktail inoculum of five strains of A. alternata isolated from tomato fruits affected by Blackmould. The optimum AOH production occurred at 0.954 a(w) after 28days of incubation at 21 degrees C. A temperature of 21 degrees C was the most favourable for AOH synthesis at all a(w) levels. The maximum concentration of AME was determined at 0.954 a(w) and 35 degrees C. The optimum conditions for TA accumulation were 0.982 a(w) and 21 degrees C. At the 0.904 a(w) no growth or germination was registered at 6 degrees C and 15 degrees C over the whole incubation period. At 21 degrees C and 35 degrees C growth occurred slowly but none of the toxins were detected at this a(w) level. In general, high a(w) levels were favourable for mycotoxin production. None of the other toxins was detected at quantifiable levels at 6 degrees C after the whole incubation period. A storage temperature of 6 degrees C or below could be considered as safe for tomato fruits and high moisture tomato products (a(w)>0.95), in relation with Alternaria toxins. The results obtained here could be extrapolated to evaluate the risk of spoilage in tomato fruits and tomato products caused by this pathogen.Copyright 2010 Elsevier B.V. All rights reserved.
Current situation of quinoa industry in China
Identification of the pathogens causing lettuce Alternaria root rot in Beijing
Alternaria taxonomy: current status, viewpoint, challenge
In:
Quinoa (Chenopodium quinoa Willd.), functional superfood for today’s world: a review
Glycerol enhances fungal germination at the water-activity limit for life
DOI:10.1111/1462-2920.13530
PMID:27631633
[本文引用: 2]

For the most-extreme fungal xerophiles, metabolic activity and cell division typically halts between 0.700 and 0.640 water activity (approximately 70.0-64.0% relative humidity). Here, we investigate whether glycerol can enhance xerophile germination under acute water-activity regimes, using an experimental system which represents the biophysical limit of Earth's biosphere. Spores from a variety of species, including Aspergillus penicillioides, Eurotium halophilicum, Xerochrysium xerophilum (formerly Chrysosporium xerophilum) and Xeromyces bisporus, were produced by cultures growing on media supplemented with glycerol (and contained up to 189 mg glycerol g dry spores ). The ability of these spores to germinate, and the kinetics of germination, were then determined on a range of media designed to recreate stresses experienced in microbial habitats or anthropogenic systems (with water-activities from 0.765 to 0.575). For A. penicillioides, Eurotium amstelodami, E. halophilicum, X. xerophilum and X. bisporus, germination occurred at lower water-activities than previously recorded (0.640, 0.685, 0.651, 0.664 and 0.637 respectively). In addition, the kinetics of germination at low water-activities were substantially faster than those reported previously. Extrapolations indicated theoretical water-activity minima below these values; as low as 0.570 for A. penicillioides and X. bisporus. Glycerol is present at high concentrations (up to molar levels) in many types of microbial habitat. We discuss the likely role of glycerol in expanding the water-activity limit for microbial cell function in relation to temporal constraints and location of the microbial cell or habitat. The findings reported here have also critical implications for understanding the extremes of Earth's biosphere; for understanding the potency of disease-causing microorganisms; and in biotechnologies that operate at the limits of microbial function.© 2016 The Authors. Environmental Microbiology published by Society for Applied Microbiology and John Wiley & Sons Ltd.
Occurrence of Chenopodium quinoa mitovirus 1 in Chenopodium quinoa in China
PAUP* 4.0b10. phylogenetic analysis using parsimony (* and other methods)
Nutrition facts and functional potential of quinoa (Chenopodium quinoa Willd.), an ancient Andean grain: a review
DOI:10.1002/jsfa.4158
PMID:20814881
[本文引用: 1]

Quinoa, Chenopodium quinoa Willd., is an Amaranthacean, stress-tolerant plant cultivated along the Andes for the last 7000 years, challenging highly different environmental conditions ranging from Bolivia, up to 4.500 m of altitude, to sea level, in Chile. Its grains have higher nutritive value than traditional cereals and it is a promising worldwide cultivar for human consumption and nutrition. The quinoa has been called a pseudo-cereal for botanical reasons but also because of its unusual composition and exceptional balance between oil, protein and fat. The quinoa is an excellent example of 'functional food' that aims at lowering the risk of various diseases. Functional properties are given also by minerals, vitamins, fatty acids and antioxidants that can make a strong contribution to human nutrition, particularly to protect cell membranes, with proven good results in brain neuronal functions. Its minerals work as cofactors in antioxidant enzymes, adding higher value to its rich proteins. Quinoa also contains phytohormones, which offer an advantage over other plant foods for human nutrition.Copyright © 2010 Society of Chemical Industry.
Isolation and identification of quinoa leaf spot and screening of biocontrol bacterium
Differentiation of virulence and identification of mycoviruses in Alternaria spp. causing pear black spot
Identification and pathogenicity of Alternaria species causing black spot in pear producing regions in China
Biological characteristics and screening of fungicides of maize Alternaria tenuis Nees
Alternaria section Alternaria: species, formae speciales or pathotypes?
DOI:10.1016/j.simyco.2015.07.001
PMID:26951037
[本文引用: 3]

Woudenberg, J. H. C.; Groenewald, J. Z.; de Vries, M.; Stielow, J. B.; Crous, P. W. CBS KNAW Fungal Biodivers Ctr, Uppsalalaan 8, NL-3584 CT Utrecht, Netherlands. Woudenberg, J. H. C.; Seidl, M. F.; Thomma, B. P. H. J.; Crous, P. W. Wageningen Univ, Lab Phytopathol, NL-6708 PB Wageningen, Netherlands. Crous, P. W. Univ Pretoria, FABI, ZA-0002 Pretoria, South Africa.
Large-spored Alternaria pathogens in section Porri disentangled
DOI:10.1016/j.simyco.2014.07.003
PMID:25492985
[本文引用: 1]

The omnipresent fungal genus Alternaria was recently divided into 24 sections based on molecular and morphological data. Alternaria sect. Porri is the largest section, containing almost all Alternaria species with medium to large conidia and long beaks, some of which are important plant pathogens (e. g. Alternaria porri, A. solani and A. tomatophila). We constructed a multi-gene phylogeny on parts of the ITS, GAPDH, RPB2, TEF1 and Alt a 1 gene regions, which, supplemented with morphological and cultural studies, forms the basis for species recognition in sect. Porri. Our data reveal 63 species, of which 10 are newly described in sect. Porri, and 27 species names are synonymised. The three known Alternaria pathogens causing early blight on tomato all cluster in one clade, and are synonymised under the older name, A. linariae. Alternaria protenta, a species formerly only known as pathogen on Helianthus annuus, is also reported to cause early blight of potato, together with A. solani and A. grandis. Two clades with isolates causing purple blotch of onion are confirmed as A. allii and A. porri, but the two species cannot adequately be distinguished based on the number of beaks and branches as suggested previously. This is also found among the pathogens of Passifloraceae, which are reduced from four to three species. In addition to the known pathogen of sweet potato, A. bataticola, three more species are delineated of which two are newly described. A new Alternaria section is also described, comprising two large-spored Alternaria species with concatenate conidia.
Influence of temperature and water activity on mycelial growth and conidia formation of Eurotium cristatum isolated from Chinese brick tea
Identification of pathogen causing downy mildew of Chenopodium quinoa
Morphology, phylogeny, and pathogenicity of Trichothecium, Alternaria, and Fusarium species associated with panicle rot on Chenopodium quinoa in Shanxi Province, China
DOI:10.1111/ppa.13462 URL [本文引用: 3]
Identification of the pathogen causing Cercospora leaf spot on quinoa
Identification, pathogenicity, and fungicide sensitivity of Ascochyta caulina (teleomorph: Neocamarosporium calvescens) associated with black stem on quinoa in China
DOI:10.1094/PDIS-09-19-2042-RE URL [本文引用: 1]
Sequence and phylogenetic analysis of endopolygalacturonase genes from Alternaria small-spored species
Study on the pycindiospore germination of apple tree Valsa canker pathogen
Phylogenetic analysis of Alternaria spp. causing black rot and brown spot of citrus in China
Isolation, identification, biological characteristic and biocontrol bacteria screening of celery leaf spot pathogen
Sequence and phylogenetic analysis of OPA2- 1 region from Alternaria small-spored species
Biological characteristics of the pathogen causing Alternaria leaf spot in sorghum
Breeding quinoa (Chenopodium quinoa Willd.): potential and perspectives
DOI:10.1007/s11032-014-0023-5 URL [本文引用: 1]
芹菜叶斑病病原菌的分离鉴定、生物学特性及其生防菌筛选